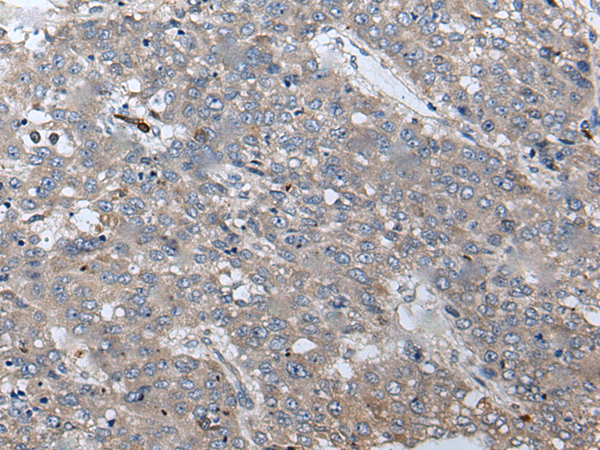

手機(jī)掃碼訪問本站

微信咨詢
技術(shù)規(guī)格
|
Background: |
The protein encoded by this gene functions to inhibit WNT proteins, which are extracellular signaling molecules that play a role in embryonic development. This protein contains a WNT inhibitory factor (WIF) domain and five epidermal growth factor (EGF)-like domains, and is thought to be involved in mesoderm segmentation. This gene functions as a tumor suppressor gene, and has been found to be epigenetically silenced in various cancers. |
|
Applications: |
ELISA, WB, IHC |
|
Name of antibody: |
WIF1 |
|
Immunogen: |
Fusion protein of human WIF1 |
|
Full name: |
WNT inhibitory factor 1 |
|
Synonyms: |
WIF-1 |
|
SwissProt: |
Q9Y5W5 |
|
ELISA Recommended dilution: |
1000-2000 |
|
IHC positive control: |
Human liver cancer and Human esophagus cancer |
|
IHC Recommend dilution: |
25-100 |
|
WB Predicted band size: |
42 kDa |
|
WB Positive control: |
Hela cell |
|
WB Recommended dilution: |
200-1000 |
|
Background: |
The protein encoded by this gene functions to inhibit WNT proteins, which are extracellular signaling molecules that play a role in embryonic development. This protein contains a WNT inhibitory factor (WIF) domain and five epidermal growth factor (EGF)-like domains, and is thought to be involved in mesoderm segmentation. This gene functions as a tumor suppressor gene, and has been found to be epigenetically silenced in various cancers. |
|
Applications: |
ELISA, WB, IHC |
|
Name of antibody: |
WIF1 |
|
Immunogen: |
Fusion protein of human WIF1 |
|
Full name: |
WNT inhibitory factor 1 |
|
Synonyms: |
WIF-1 |
|
SwissProt: |
Q9Y5W5 |
|
ELISA Recommended dilution: |
1000-2000 |
|
IHC positive control: |
Human liver cancer and Human esophagus cancer |
|
IHC Recommend dilution: |
25-100 |
|
WB Predicted band size: |
42 kDa |
|
WB Positive control: |
Hela cell |
|
WB Recommended dilution: |
200-1000 |